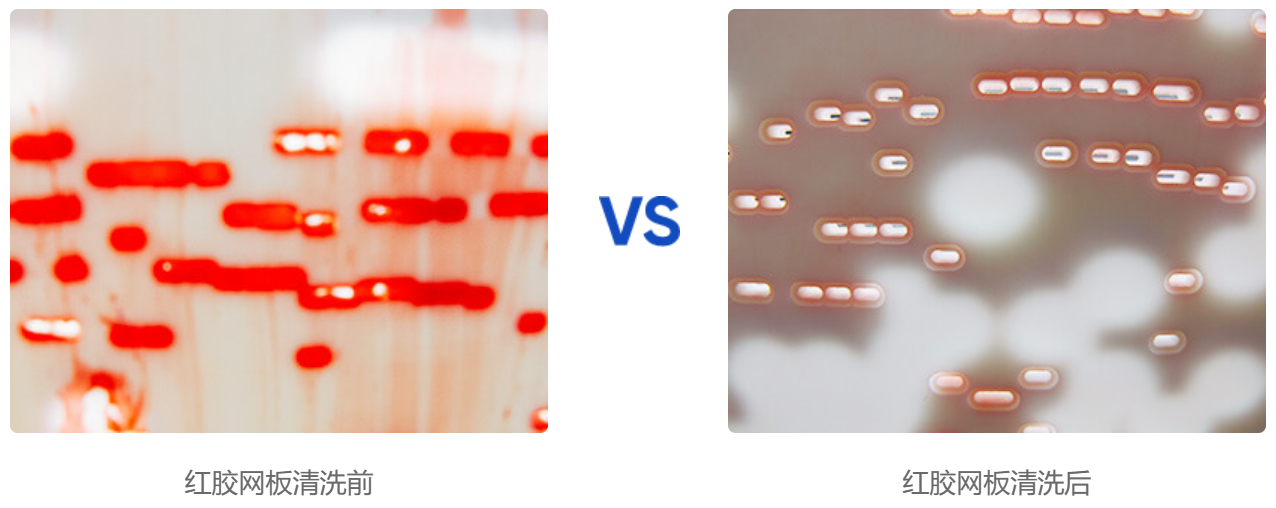

红胶网板清洗
目前在电源、白色家电行业的波峰焊工艺中,前段的红胶贴装是一项必不可少的工艺过程。
在早期的红胶网板清洗工艺中,对于错印版和塑胶、以及铜板厚网清洗是使用挥发性有机溶剂的喷淋清洗。
随着社会对于环保和安全的要求越来越高。红胶网板清洗,尤其是目前仍然被行业内广泛使用的气动喷淋清洗机清洗机存在诸多的不如意。
由于喷淋的力道是线性的,对于深孔和结构较为复杂的并型塑网式铜网就很难清洗干净,需要多次清洗。而超声波产生的空化力的传播弥散开来的,可以进入每一个角度,从而清洗干净。
所以,对于清洗红胶网板来说,选择产品和设备至关重要。
一是选择一款对红胶有比较好溶解力的水基清洗剂;
二是要选择利用超声波的物理力使得红胶更快地分散和溶解以达到完成清洗的效果。
![[x]](/template/default/picture/closeimgfz1.svg)